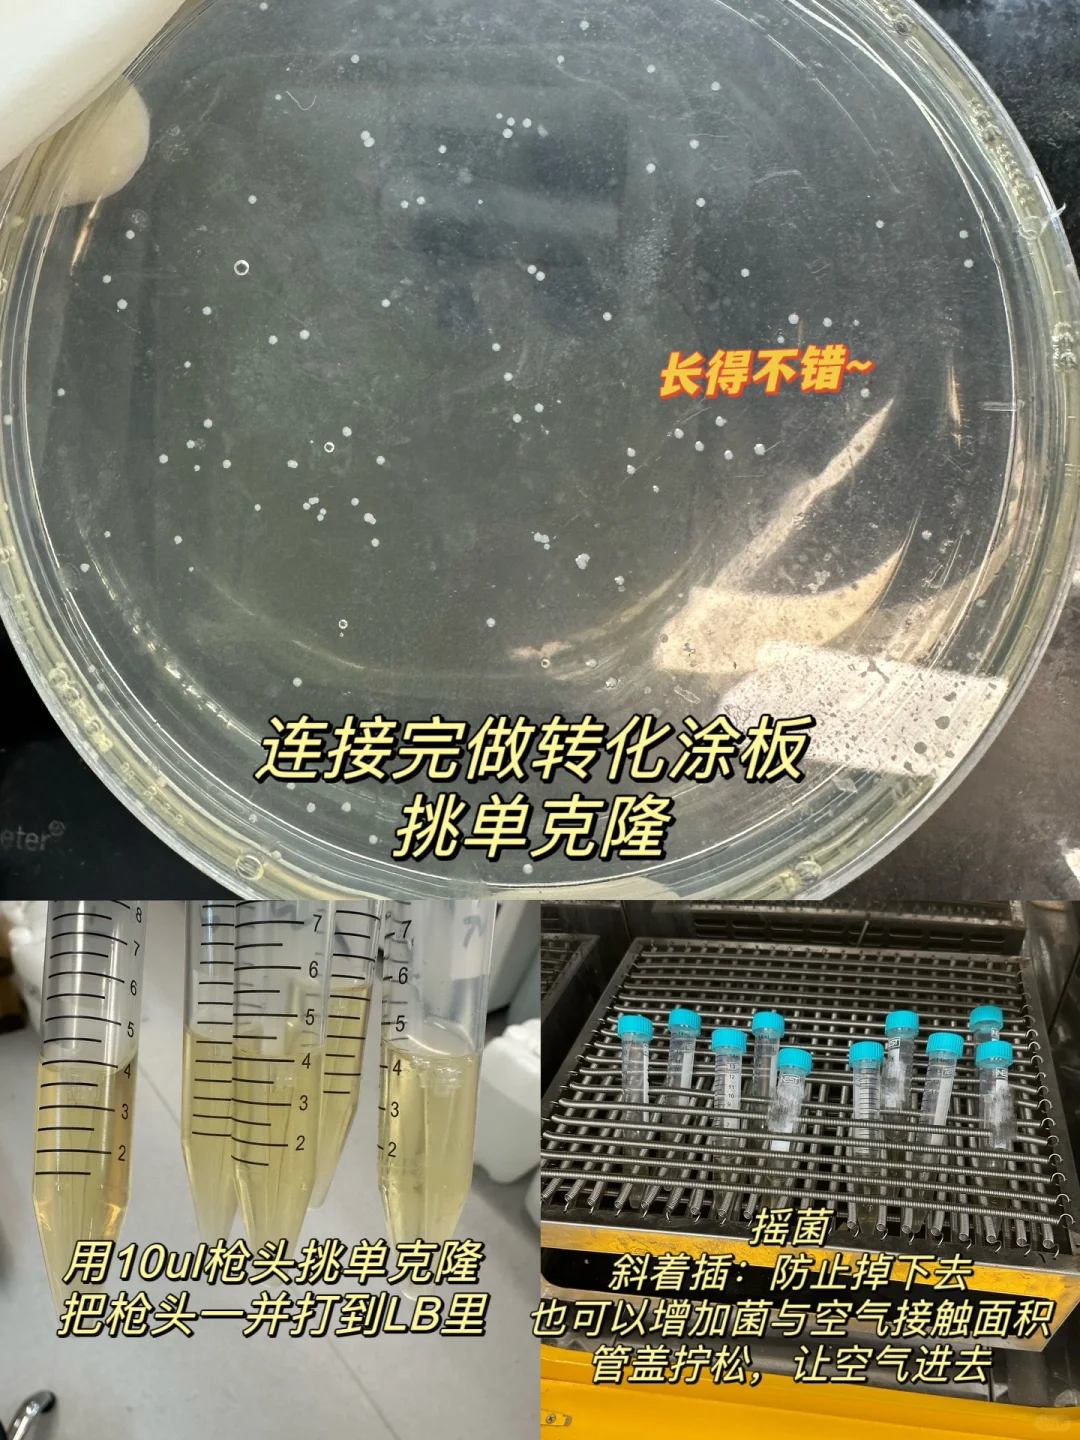

最近构建了5个新基因的质粒,都成功了。
从研一都现在至少做过20多个质粒了,过表达,敲低,突变,截断都做过…
个人感觉野生型和sg是相对来说有难度的,突变体质粒是最简单的,今天分享一些个人构建野生型plasmid的小经验和小技巧,码住吧各位,肯定对你们有帮助的。[派对R]
1、订引物:前后引物TM值相差不宜过大,最好在3度之内。之前分享过质粒构建的引物设计详细教程,这里不赘述了,不会的区翻前面的笔记。
2、PCR:拿到引物后先计算TM值,前引物加后引物再除以2,如果TM值差别较大,参考前后引物中比较小的那个值,以算出来的理论TM值为中心,各加减2度,做温度梯度先少量pcr。
3、PCR后琼脂糖验证:跑凝胶看条带亮度(如1图所示),选择条带最亮的那个温度大量P,一般p 100ul就够了。(图2,条带单一,亮即可)
4、纯化回收:大量p完后纯化回收pcr产物,或者切胶回收。这里回收肯定会损失,单一峰,浓度20+都可以用,浓度低点没事。
5、双酶切:pcr产物和载体一起切,根据说明书做就可以,pcr产物浓度低的话酶切完就别回收!!!!直接验证连接。
6、酶切后验证:个人这里只验证载体是否切开,只要载体切开了,pcr产物肯定也切开了。
跑胶:未切开的载体环状跑得快并且会拖尾;切开的线性载体跑的慢不会拖尾。(图3)
7、连接:用T4连接酶,连接时间久一些,说明书写的10min,我一般连接30min以上。
8、做转化:把连接产物全部做转化,用50ul感受态,做完转化后+100ul 无抗性LB,37度摇1小时以上,充分激活感受态,摇完之后涂板。
9、涂板:所有的转化产物全涂!!!成功率会高很多。(可以瞬离一下涂沉淀),新构建的质粒会长得慢,37度培养箱放12个小时+,等菌长大的时候再挑单克隆。(图4)
10、摇菌:挑单克隆小摇,个人每个板子挑3~5颗菌,全部送去测序。
⚠️摇菌注意:用10ul小枪头挑,直接把枪头打进管里,37度摇床摇菌时,把离心管盖拧松斜着插。
一方面让大量空气进去,斜着插增加大肠杆菌和空气的接触面积,另一方面防止管子钓掉摇床下面。